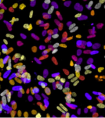

新闻资讯
本专题为癌症123的癌症专题,内容全部来自癌症123精心选择与癌症相关的最近资讯,癌症123读懂智能与未来,拥有癌症资讯的信息,在这里你能看到未来的世界。
*以上解读内容仅供参考,癌症123不对解读内容负责。
小病不治,大病难医!这10种小毛病最容易拖成癌,可惜知道的人太少了!
2017-06-25人吃五谷孰能无病?很多人即使没有生大病,也会有小病小痛,有的小病无需吃药,扛一扛自己就会好,但有的病却不能拖,因为拖久了可能会变成癌症。专家表示,有些癌症的发病潜伏期高达10年,常常因为...
首个!FDA 批准多生物标志物的 NGS 伴随诊断,靶向 4 种抗癌药
2017-06-25伴随诊断,指导“同病异治”伴随诊断是一种与靶向药物相关联的体外诊断技术,主要通过检测人体内蛋白、突变基因的表达水...
违背直觉!癌细胞为了快速壮大队伍,“简化”基因序列
2017-06-256 月 22 日,《PLoS Genetics》期刊发表一篇题为“Ribosomal DNA copy number loss and sequence variation in cancer...
生成血管的细胞也可以生成肿瘤并助其成长
2017-06-24奥古斯塔州立大学乔治亚医学院病理系癌症生物学家 Lan Ko 博士说:“当我们意识到生成血管的细胞可以形成肿瘤,整个图像变成一个循环。” 发表在 Oncota...
哪类人更容易得肾癌和膀胱癌?
2017-06-24一项新的研究表明,为什么一生坐在沙发上不利于您的健康,增加了肾脏和膀胱癌的更大风险。 具体来说,终身不参与娱乐活动可能导致膀胱癌风险增加 73%,肾癌...
Science 子刊:癌细胞抗药性竟能传染!
2017-06-24最近,加州大学圣地亚哥分校(UCSD)的科学家们发现,不同癌细胞之间可以通讯,通过激活一种胞内机制,增强对常见化疗药物的抗性,从而促进肿瘤的存活。这一研究结果发表在近期的《科学》...
科学家找到成功“饿死”癌细胞的天然化合物
2017-06-24德克萨斯大学奥斯汀分校的研究人员发现了一种有潜力的天然化合物,这种化合物可以成功“饿死”前列腺癌癌细胞,使肿瘤缩小。这种化合物存在于姜黄,红葡萄...
本月初,一种名为 Burtomab 的单克隆抗体药物,在经过 14 年临床研究后,终于获得了美国 FDA“突破性疗法”认证 [1]! 该药在治疗转移至中枢神经系统的神经母...
默克、阿斯利康等药企或在人排泄物中找到新的癌症疗法
2017-06-24根据彭博资讯报道,先前已有研究表明人类大便中上万亿的微生物和开发癌症免疫疗法是有关联的,而如今,至少有 5 - 6 个初创生物科技公司正在参与将这种基...
科学家找到彻底消灭癌细胞的“新武器”
2017-06-24发表于《细胞》杂志中的最新研究详细阐述了,死亡细胞如何被取代,如何利用微生物杀死癌细胞,基于这一发现,研究人员找到减少癌变肿瘤的新方法。 研究人员...
癌症:免疫疗法溶瘤病毒与 PD- 1 药物结合,抗癌效果倍增
2017-06-24横纹肌肉瘤是一种骨骼肌细胞癌症,是常见儿童软组织肿瘤。传统的手术治疗通常是可以治愈的,但是需要加入化疗和放疗结合治疗,其中充满了严重的副作用,尤其...
科学家说他们已经解锁了减慢癌症转移的“秘密”!
2017-06-24Hasini Jayatilaka 是约翰·霍普金斯大学的大二学生,在实验室研究癌细胞的时候,当时她注意到,当细胞变得太密集时,有些会破裂并开始传播。 她不知道该怎么...
研究发现影响肺癌患者存活时间的重要因素!
2017-06-24近年来,免疫治疗是一种新兴的攻击肿瘤细胞的癌症治疗技术,吸引了大众的想象力。当它发挥作用时,结果是惊人的。但是,通常情况下,科学家们仍然不知道为什么...
对付难治性癌症,从各个角度提供见解!
2017-06-24在我们承诺增加未满足需求的癌症研究经费的三年中,我们增加了四个确定的重点癌症 - 肺,胰腺,食管和脑的癌症研究支出。我们在 2016/17 年度为这四种疾病...
阻断致癌蛋白质——抗击癌症新进展!
2017-06-24来自自然化学生物学杂志发表的新发现表明,他们希望找到治疗肺癌和其他致命疾病的新方法。肯塔基州继续位居国家肺癌的发病率和死亡率榜首,肯塔基大学致...
如何更有效地利用现有药物对抗癌症?研究人员提出新方法
2017-06-24麦克马斯特大学的一个研究小组已经确定了癌症干细胞的一个独特特征,可以被用来杀死致命的细胞,被认为是治疗后癌症复发的原因。了解此功能将有助于将更...
辉瑞、默克将与 Effector Therapeutics 开展癌症免疫组合疗法
2017-06-246 月 20 日,Effector Therapeutics 表示,公司已于美国辉瑞制药及德国默克制药达成了一项临床开发及药品供应合作协议,双方将共同进行两种肿瘤免疫治疗药...
Cell:科学家利用新方法鉴定肿瘤免疫治疗新靶点
2017-06-232017年5月,《Cell》杂志连续刊登了美国西奈山伊坎医学院研究人员的工作,他们分离了来自肺癌病人肿瘤组织、正常肺组织以及外周血的免疫细胞,利用TCR测序和质谱流式(CyTO...
双靶点成功治疗多发性骨髓瘤
2017-06-23多发性骨髓瘤是三大血液系统恶性肿瘤之一,患者全身骨痛无法行走和正常生活,目前无法治愈。记者6月21日获悉,南京传奇生物科技有限公司...
食管癌“免管免禁”疗法登录外科圣典
2017-06-23河南省肿瘤医院李印教授团队食管癌加速康复的“免管免禁”疗法,近日在国际外科领域权威杂志《外科学年鉴》在线发表。这一研究有望...
解决脑瘤靶向用药 粘性纳米颗粒来帮忙
2017-06-23日前,耶鲁大学(Yale University) 的研究团队在《自然》子刊《Nature Communications》发表论文表明,通过改变纳米颗粒(na...
中老年男性如何订制“查癌体检单”
2017-06-236月第三个周日是父亲节。父爱如山,父亲宽厚的肩膀扛起家庭的欢乐和幸福,父亲坚毅的背影,守护世界上最温暖的港湾。父爱无以为报,唯愿他健康平安。上海市抗癌协会秘书长、复旦大学附属肿瘤...
乳腺癌是怎么来的,听听中医怎么说?
2017-06-23导致人身体不健康,有这“四种气”,都伤乳腺。乳腺癌的病情高发,超过一半来自情绪的负能量。有那“四种气”呢?1、怨气: 来源于一种怨恨的情绪。 2、闷气: 多发生在夫妻之间,两人...